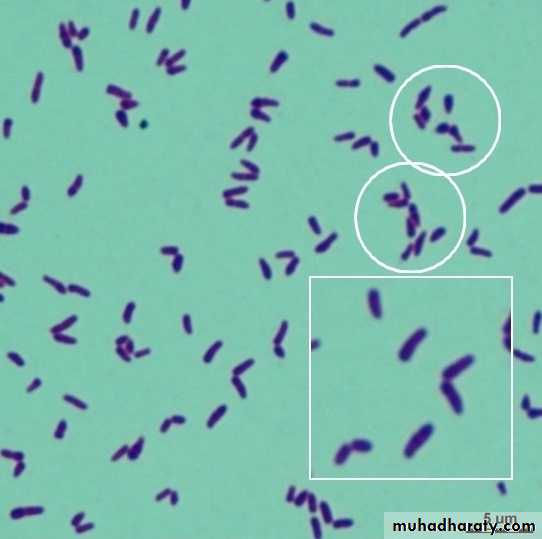
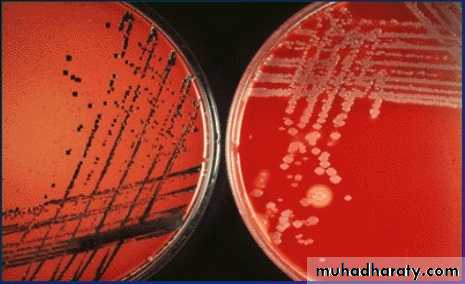

Gram Positive Bacilli Corynebacterium diphtheria
Corynebacterium diphtheria
Corynebacterium are club-shaped gram-positive, non-capsulated, non-spore forming, non-motile rods.Chinese letter or cuneiform arrangement in smear (V or L shaped).
Metachromatic granules (volutin) present at ends or poles of bacilli.
They are storage granules composed of polymetaphosphate.
They are better stained with special stains, such as Albert’s stain.
Diphtheria: (Toxigenic Corynebacterium diphtheria).
Is an acute respiratory or cutaneous disease and may be life threatening. The development of effective vaccination protocols and widespread immunization beginning in early childhood has made the disease rare in developed countries, diphtheria is a serious disease throughout the world, particularly in those countries where the population has not been immunized.Corynebacterium diphtheria
Epidemiology:Found in the throat and nasopharynx of carriers and in patients with diphtheria.
This disease is a local infection.
Usually present in throat, and the organism is primarily spread by respiratory droplets,
It is less frequently spread by direct contact with an infected individual or a contaminated fomite.
Corynebacterium diphtheria
Pathogenesis:Diphtheria is Toxemia but Never a Bacteremia.
Bacilli are noninvasive, present only at local site (pharynx), secrete the toxins which spread by bloodstream to various organs.
It is the toxin which is responsible for all types of manifestations including local (respiratory) and systemic complications (except the skin lesions which may be caused due to the organism).
Diphtheria toxin (A-B component) inhibits protein synthesis by adding ADP-ribose to eEF-2 (Elongation Factor-2).
Effect on oropharynx: Dirty gray pseudomembrane (made up of dead cells and fibrin exudate, bacterial pigment).
Extension into larynx/trachea → obstruction.
Effect of systemic circulation → heart and nerve damage.
Corynebacterium diphtheria
Pathogenesis:The host response to Corynebacterium diphtheriae consists of the following:
• A local inflammation in the throat, with a fibrinous exudate that forms the tough, adherent, gray pseudomembrane characteristic of the disease.
• Antibody that can neutralize exotoxin activity by blocking the interaction of the binding domain with the receptors, thereby preventing entry into the cell.
Entry the bacilli multiply locally in the throat and elaborate a powerful exotoxin produced local and systemic symptoms.
Local lesions
Exotoxin causes necrosis of the epithelial cells and liberates serous and fibrinous material which forms a grayish white pseudo membrane.
The membrane bleeds on being dislodged Surrounding tissue is inflamed and edematous.
Corynebacterium diphtheria
Clinical Finding:
• Respiratory Diphtheria:
Tonsil and pharynx (faucial diphtheria) are the most common sites followed by nose and larynx and rarely non-respiratory mucosa, such as conjunctiva or vagina. Incubation period is about 3–4 days:-
Faucial diphtheria: Toxin elicits an inflammatory response that leads to necrosis of the epithelium and exudate formation leading to formation of pseudomembrane (tough leathery greyish white coat composed of an inner band of fibrin surrounded by neutrophils, RBCs and bacteria).
Pseudomembrane is so named, as it is adherent to the mucosal base and bleeds on removal.
Extension of pseudomembrane: In severe cases, it may extend into larynx and medium sized bronchial airways which may result in fatal airway obstruction leading to asphyxia, which mandates immediate tracheostomy.
Bull-neck appearance: Characterized by massive tonsillar swelling and neck edema.
Corynebacterium diphtheria
Clinical Finding:• Cutaneous Diphtheria:
Characterized by punched-out ulcerative lesions with necrosis, or rarely pseudomembrane.
Cutaneous diphtheria is due to the organism itself and is not toxin mediated.
Skin lesions can also be caused by nontoxigenic strains.
There is increasing trend of cutaneous diphtheria nowadays, especially in vaccinated children, because antitoxins present in vaccinated people cannot prevent the disease.
• Systemic Complications:
Neurologic manifestations (cranial nerve involvement, Peripheral neuropathy, ciliary paralysis) and myocarditis are late toxic manifestations, occurring after weeks of infection.
Corynebacterium diphtheria
Laboratory Diagnosis:Note: Because of risk of respiratory obstruction, specific treatment should be instituted immediately on clinical suspicion of diphtheria without waiting for laboratory reports.
• Specimen: Throat swab (one or two) containing fibrinous exudates and a portion of membrane.
• Direct smear microscopy:
• Gram stain: Corynebacterium diphtheria appears as irregularly stained club shaped gram-positive bacilli arranged in Chinese letter or cuneiform arrangement (V or L shaped). It is difficult to differentiate them from other commensal coryneforms found in the respiratory tract.
• Albert’s stain is more specific for C.diphtheriae, where they appear as green bacilli with bluish black metachromatic granules.
•
Gram stain
Albert’s stainCorynebacterium diphtheria
Laboratory Diagnosis:• Culture media:
Enriched medium: such as Loeffler’s serum slope.
Selective medium: such as Potassium tellurite agar (PTA).
Potassium Tellurite Agar
Blood AgarBlood Agar
Corynebacterium diphtheria
Laboratory Diagnosis:• Toxin Demonstration:
Elek’s gel precipitation test.
Detection of tox gene by PCR.
Detection of diphtheria toxin by ELISA or immunochromatographic test (ICT).
Cytotoxicity produced on cell lines.
Corynebacterium diphtheria
Treatment:• Anti Diphtheritic horse serum or ADS (antitoxin): It is the treatment of choice as it neutralizes the toxin.
• Antibiotics: Penicillin or erythromycin is the drug of choice. Antibiotic plays a minor role as it is of no use once the toxin is secreted. However, antibiotics are useful:
If given early (< 6 hrs of infection), before the toxin release.
Prevent further release of toxin by killing the bacilli.
Treatment for cutaneous diphtheria.
• Treatment of carriers: Drug of choice is erythromycin.
Corynebacterium diphtheria
Prophylaxis (Vaccination):Active immunization is done by diphtheria toxoid that induces antitoxin production in the body.
diphtheria toxoid (Usually given as a combination of Diphtheria toxoid, Tetanus toxoid, and acellular Pertussis vaccine, often abbreviated as DTaP).
Diphtheria toxoids are commonly combined with tetanus toxoid (Td) and with acellular pertussis vaccine (DaPT) as a single injection to be used in initial immunization of children (three doses in the first year of life, 15–18 months of age and 4–6 years of age).
Herd immunity of > 70% is required to prevent epidemic spread of diphtheria.
However, vaccine is not effective for:
• Prevention of cutaneous diphtheria.
• Elimination of carrier stage.